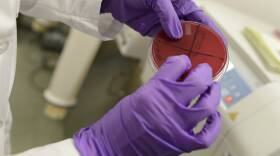
DSC_6938_lede.jpg

-
"Hidden Brain" Host Discusses Psychology Of Coronavirus
Shankar Vedantam's appearance at Boston's Wilbur Theatre was postponed due to coronavirus concerns -
Coronavirus Symptoms: Defining Mild, Moderate And Severe
These designations are often used to describe a patient's COVID-19 symptoms. At this stage of the outbreak, there aren't standard definitions but there are preliminary guidelines. -
Measuring Microplastics In Our Waterways
Draper is working on a way to efficiently measure microplastics that end up in the watershed. -
SpaceX Successfully Lands 50th Rocket In 5 Years
The commercial rocket company sent its "Dragon" capsule from Cape Canaveral to the International Space Station on Friday for its 20th resupply mission. It's due to arrive at the space station Monday. -
First Vaginal Bacteria Transplants In The US To Begin At Mass. General Hospital
Researchers in Boston are looking for a better treatment for Bacterial Vaginosis, a condition affecting one-third of women in the country. -
States Take The Wheel Promoting Electric Vehicles
There are nearly 1.5 million electric vehicles in the U.S. today. E.V. boosters want more government incentives to increase that. With little federal movement states like New Jersey are taking action. -
Home DNA Tests Reveal More Than We Bargained For
Nobody really knows who will have access to our genetic data in the years to come. Here’s why that’s scary. -
Harvard Business School Professor Reflects On Jack Welch
The Former General Electric CEO and Massachusetts Native Has Died At 84 -
How The Brain Teases Apart A Song's Words And Music
Brain scans show that when people listen to songs, an area in the left hemisphere decodes speech-like sounds while one on the right processes musical information. -
NOVA Explores The ‘Mysteries Of Sleep’
A new documentary film, ‘The Mysteries of Sleep,’ explores the vital role that sleep plays in neurological development, mental and physical health, and more.